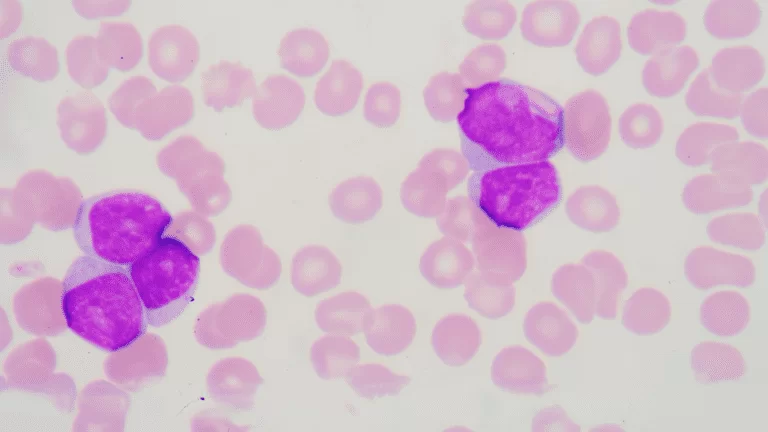
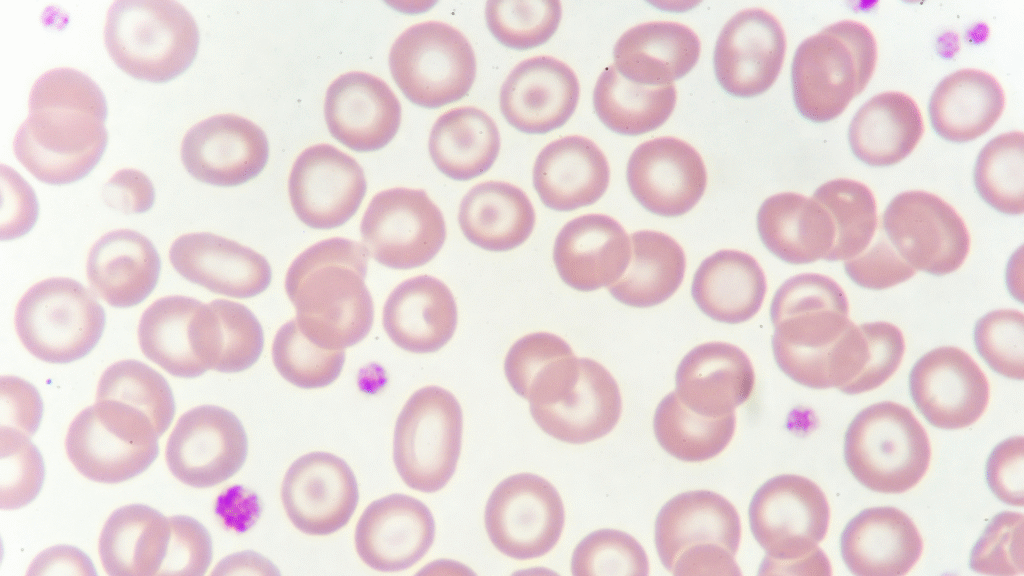
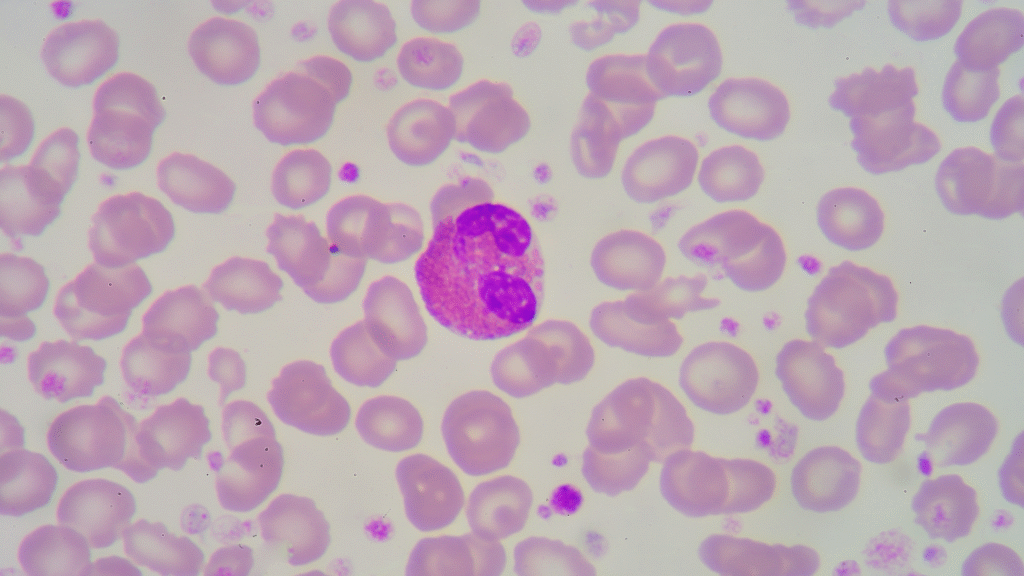
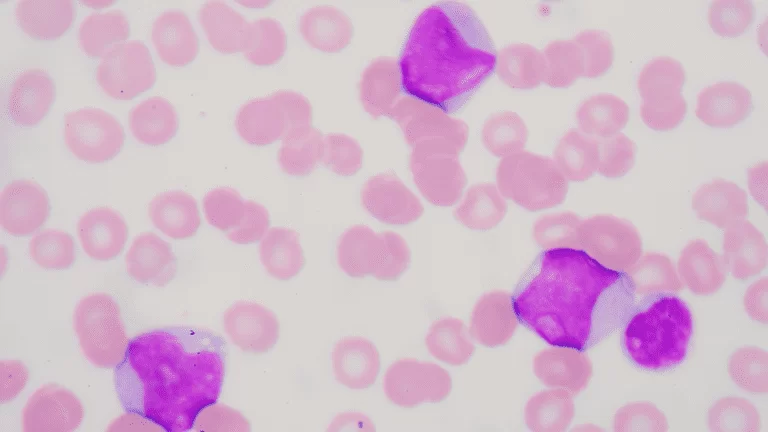

Garanta sua vaga agora e aproveite condições especiais antes que o prazo acabe.
Domine a Hematologia Laboratorial com aulas práticas e foco na rotina do laboratório.


que atuam ou pretendem atuar em análises clínicas.

interessados em diagnóstico laboratorial e pesquisa em hematologia.

que buscam aprimorar sua atuação em laboratórios de análises clínicas.

que desejam ampliar sua compreensão dos exames hematológicos.


Aprenda com o Prof. Dr. Luiz Arthur Calheiros, referência nacional em Hematologia Laboratorial.

Acesso imediato às aulas gravadas + treinamentos práticos ao vivo.

Conclua o curso e receba certificado de 40 horas válido em todo o Brasil.

Mais de 1.000 lâminas e 100 casos clínicos para você dominar o hemograma.
Participe de uma experiência completa em Hematologia Laboratorial, com foco em leitura de lâminas, hemogramas e interpretação clínica.

Fase Pré-Analítica
– Coleta do material
– Ordem e Análise dos tubos
– Hemólise e Lipemia
– Volume do Tubo e Recoleta
– Erros pré-analíticos

Esfregaço e Coloração
– Prática de Esfregaço Sanguíneo
– Prática de Coloração com May-Grunwald-Giemsa
– Análise da Lâmina por microscopia

Valores de Referência
– Valores de referência da série vermelha, branca e plaquetas
– Valores de referência em RN, crianças, adultos e idosos.
Morfologia na Prática
– Leitura de Lâminas com morfologia de células normais e anormais do sangue
– Casos clínicos reais com dados do hemograma, leitura de lâminas com contagem de células (01 a 100)
– Diferenciação prática das células do sangue
Anemias
– Eritropoese e Hemácias
– Anemias: conceito, tipos, sintomas e parâmetros
– Eritrograma: detectando a anemia
– Morfologia Eritrocitária
– Anemia Ferropriva
– Anemia megaloblástica
– Anemia Normocítica
– Anemias Hemolíticas e Reticulócitos
– Anemia Falciforme
– Talassemias
– Outras Anemias Hemolíticas
Leucócitos
– Introdução aos Leucócitos
– Neutrófilos
– Linfócitos
– Eosinófilos
– Monócitos
– Basófilos

Plaquetas
– O que são e como são formadas
– Plaquetograma
– Plaquetopenia
– Contagem de Plaqueta na Prática
– Pseudoplaquetopenia e Medidas Corretivas
– Trombocitose
Neoplasias
– Introdução às Neoplasias Hematológicas
– Leucemias Agudas – Conceito, Clínica e Diagnóstico
– LMA: hemograma, morfologia e casos clínicos
– LLA: hemograma, morfologia e casos clínicos
– LMC: hemograma, morfologia e casos clínicos
– Neoplasias Mieloproliferativas: hemograma, morfologia e casos clínicos
– LLC / Neoplasias Linfoproliferativas: hemograma, morfologia e casos clínicos
– Linfomas: hemograma, morfologia e casos clínicos
– Morfologia das Leucemias Agudas
– Morfologia na Doenças Mielóides Crônicas
– Morfologia na Doenças Linfóides

Automação com Gráficos
– Base da Automação em hematologia
– Eritrócitos
– Leucócitos
– Equipamentos Hematológicos
– Critérios de Revisão

Coagulação e Anticoagulação
– Fisiologia da Coagulação
– Trombose
– Laboratório e Coagulação
– Anticoagulação
– CIVD e Caso Clínico

Imuno-Hematologia
– Introdução à Imuno-Hematologia
– Sistema ABO
– Sistema Rh

Casos Clínicos
Casos clínicos com hemograma e morfologia de doenças como:
– Anemia Falciforme
– Púrpuras
– Leucemia Promielocítica
– Mononucleose com Linfócitos Reativos
– Talassemia
– Trombocitemia essencial
– LMA, LLA, LMC, LLC
– Eliptocitose hereditária
– Anomalia de Pelger Huet
– Linfomas
– e muito mais!


O curso superou minhas expectativas! O conteúdo é atualizado, os professores são altamente qualificados e aplicáveis ao dia a dia do laboratório. Me sinto muito mais segura para atuar em áreas como hemograma e mielograma.
Ana Paula Souza
Biomédica
A estrutura é excelente. Mesmo sendo EAD, as aulas são didáticas, bem organizadas e os estudos de caso ajudam muito na prática clínica. Com certeza agregou muito à minha carreira.
Rafael Lima
Farmacêutico
Recomendo a todos que querem se aprofundar na área! Aprendi muito sobre citometria, biologia molecular e interpretação de exames laboratoriais. Um diferencial no meu currículo.
Camila Torres
Bióloga
Esse curso me proporcionou crescimento profissional e pessoal. O suporte da equipe é ótimo, os materiais são completos e realmente focados na prática laboratorial.
Lucas Menezes
Técnico em Análises Clínicas
Com essa especialização, consegui uma promoção no laboratório onde trabalho. Hoje me destaco como referência em hematologia dentro da minha equipe.
Juliana Rocha
Biomédica

Prof. Dr. Luiz Arthur Calheiros que é Fundador e Diretor da LaHemato EaD, autor do livro Atlas do Sangue Periférico e Doenças Hematológicas (2019), professor de Pós-Graduação, consultor em Hematologia Laboratorial com mais de 20 anos de experiência, Doutor em Bioquímica e Fisiologia (UFPE), Mestre e Especialista em Hematologia (UNIFESP), com proficiência técnica reconhecida pela SBHH.
Ambiente seguro. Seus dados estão protegidos e sua compra é 100% segura.
Seu login e senha serão enviados ao seu e-mail logo após o pagamento.
Você poderá pedir a devolução de 100% do seu dinheiro dentro desse prazo.
De R$ 357 por:
R$197
Informações sobre a curso:

Estude grátis por 7 dias e comprove a qualidade. Se não gostar, devolvemos todo o seu investimento, sem burocracia.